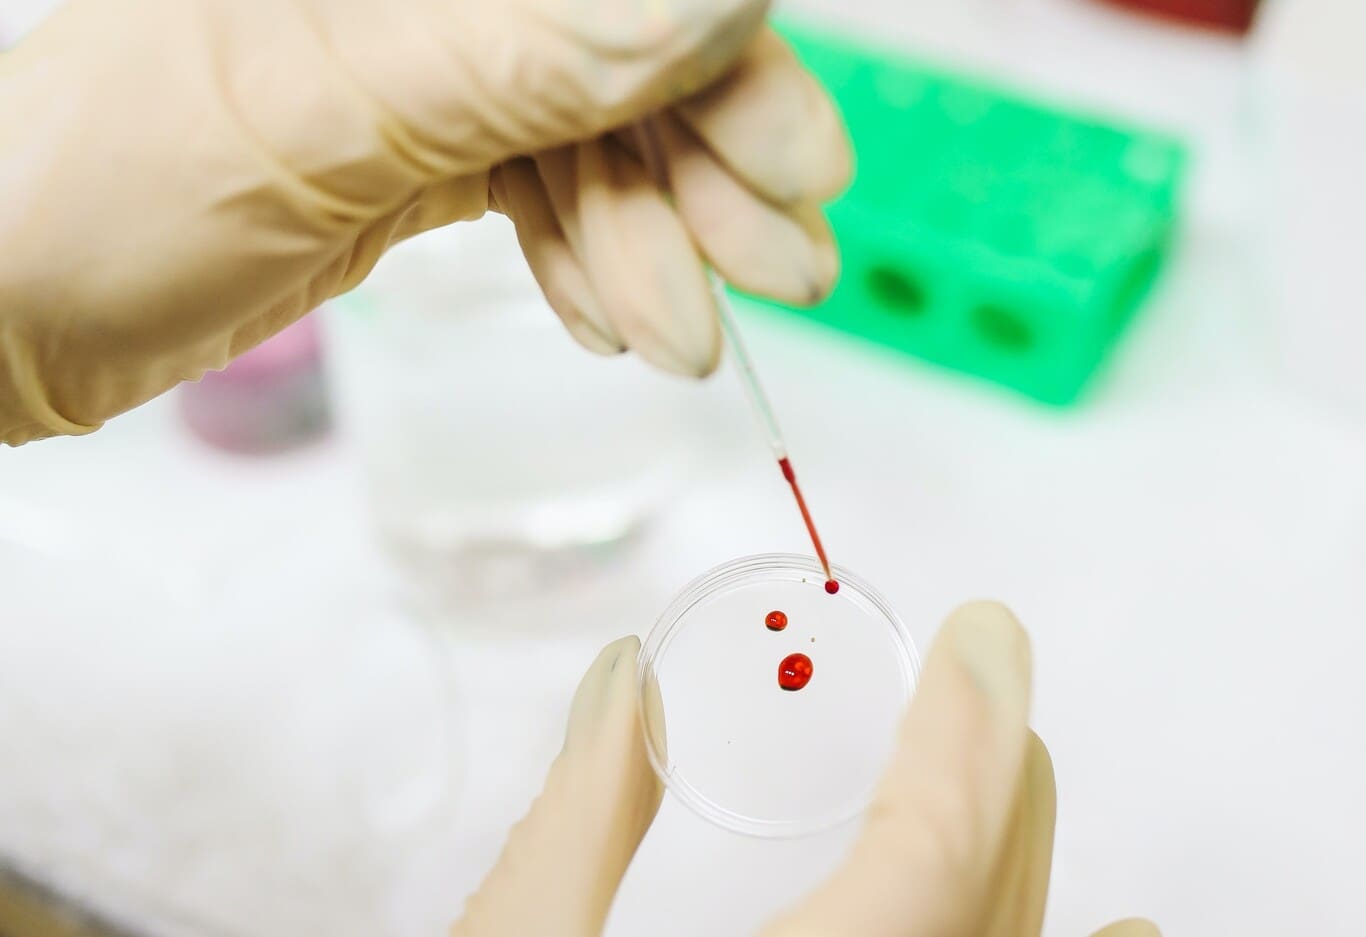

Salud y Familia
Uno de cada cuatro mexicanos ha sido infectado con SARS-CoV-2, el virus que causa COVID, según datos preliminares de la SSA
La Encuesta Nacional de Salud y Nutrición (ENSANUT) se anunció en agosto pasado, con el propósito de tomar muestras en personas y saber cuánta población tiene anticuerpos contra SARS-CoV-2 a partir de una muestra representativa. Los primeros resultados ahora son oficiales: el 25% de la población en México ha estado infectada por el virus que causa COVID.
Desde luego, las infecciones pudieron haber producido el síndrome clínico, o bien, pudieron haber sido pacientes asintomáticos.
Una encuesta pasa saber cómo va realmente México en contagios
La encuesta funciona a través de un muestreo en 9,400 hogares, de los cuales Secretaría de Salud ha tomado ya muestras en el 74.4% de los casos. Por tanto, los datos tienen todavía carácter de preliminar y pueden ajustarse una vez que se analice el último cuarto de la muestra. Lo que sí se sabe, hasta ahora, es que aproximadamente 31 millones de mexicanos han estado infectados en algún punto de febrero hasta la fecha.

Con base en los mismos datos presentados, siete de cada diez infectados nunca tuvo síntomas; uno de cada diez tuvo algún síntoma y dos de cada diez sí tuvieron varios síntomas.
Los datos todavía preliminares revelan que en las personas entre 20 59 años hay mayor proporción de infección. En donde hay menos contagios es en las personas de 60 y más años. La tesis aquí es que las personas de ese rango de edad se cuidaron más y se resguardaron en casa.

Las personas con educación superior son quienes tienen menor proporción de contagios.
Los datos completos de la encuesta serán presentados en el primer semestre del próximo año.
-

 Zitácuaro9 horas ago
Zitácuaro9 horas agoIxtláhuac Orihuela confirma aspiraciones al 2027, pero prioriza estabilidad municipal y evitará separación prolongada
-

 Zitácuaro9 horas ago
Zitácuaro9 horas agoOfrecen Asesoría Jurídica y Psicológica Gratuita en las Mesas de orientación del Día Naranja en Zitácuaro
-

 Congreso1 día ago
Congreso1 día agoMary Carmen Bernal defiende política de infraestructura y soberanía nacional de la administración federal
-

 Michoacán1 día ago
Michoacán1 día agoAlfredo Ramírez Bedolla eleva a 82 mil la meta de viviendas y entrega las primeras unidades en Yurécuaro
-

 Michoacán11 horas ago
Michoacán11 horas agoFGE y fuerzas federales detienen a presunto líder delincuencial implicado en extorsiones y homicidios
-

 Política2 días ago
Política2 días agoTribunal de Justicia Administrativa de Michoacán inhabilita por 20 años al diputado Juan Carlos Barragán Vélez
-

 Michoacán2 días ago
Michoacán2 días agoBomberos de Zitácuaro auxilian a dos personas intoxicadas dentro de una cisterna en la colonia El Hucaz
-

 Michoacán2 días ago
Michoacán2 días agoSecretaría de Salud intensifica la vigilancia epidemiológica por repunte de casos de VIH



